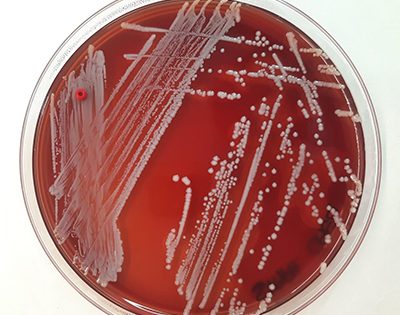

Tag: Staphylococcus caeli
-
IZS Ve identifica una nuova specie di stafilococco proveniente dall’aria: Staphylococcus caeli
Il Laboratorio di batteriologia speciale della sezione di Treviso dell’Istituto Zooprofilattico Sperimentale delle Venezie (IZSVe) ha identificato e dato il nome a una nuova specie di stafilococco. Il genere stafilococco è costituito da diverse specie di batteri Gram positivi ampiamente diffusi in natura. Alcune di queste specie sono comuni abitanti della pelle e delle mucose ...